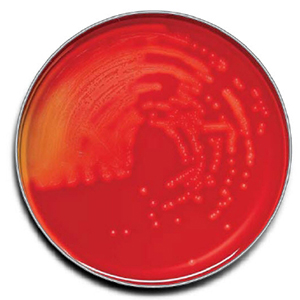
BD BBL Trypticase Soy Agar with 5% Sheep Blood Plate, 100/Pack

BD BBL Trypticase Soy Agar with 5% Sheep Blood Plate, 100/Pack
This product is also in these categories:
Product Information:
- Products Model: 221261
- Product Brand: BD
- Condition: New
- This special-order item ships in an estimated 4-6 weeks.
- Warranty: Satisfaction Guaranteed
Trypticase™ Soy Agar with 5% Sheep Blood (TSA II™), 100/pk (NOTE: Product is short-dated) (Continental US Only)
Your Dynamic Snippet will be displayed here...
This message is displayed because youy did not provide both a filter and a template to use.